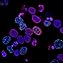

Unlock the Power of Stem Cell Technology With Dan Fee & Linda Peltz
Impossible d'ajouter des articles
Désolé, nous ne sommes pas en mesure d'ajouter l'article car votre panier est déjà plein.
Veuillez réessayer plus tard
Veuillez réessayer plus tard
Échec de l’élimination de la liste d'envies.
Veuillez réessayer plus tard
Impossible de suivre le podcast
Impossible de ne plus suivre le podcast
-
Lu par :
-
De :
À propos de ce contenu audio
Looking for a natural way to feel younger, sharper, and more energized? Learn how Lifewave’s X39 patches, copper peptides, and glutathione support can help activate your body’s own stem cells—naturally.
💥 Visit: www.startx39now.com
💡 Discover how glutathione—your body’s master antioxidant—can improve recovery, clarity, and immune function.
📚 Check out the science! Published reports available on PubMed.
🐾 They even have a program for pets—because your furry friends deserve wellness too!
📍 Meet Dan & Barb Fee at the Clovis, CA Farmers Market every Friday!
Learn firsthand, try a patch, and ask questions. Great for:
Realtors who need to stay sharp
Professionals in ANY industry

Vous êtes membre Amazon Prime ?
Bénéficiez automatiquement de 2 livres audio offerts.Bonne écoute !
Aucun commentaire pour le moment